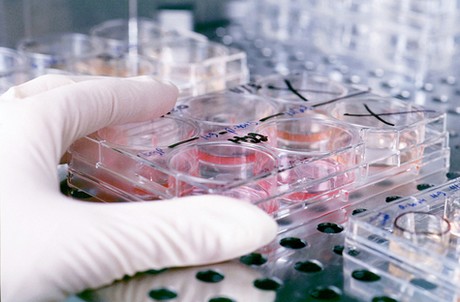

Andalucía financia nueve estudios de investigación para afinar el pronóstico y tratamiento del Covid-19
El programa desarrolla proyectos y ensayos clínicos en hospitales andaluces que permitirán conocer mejor la enfermedad y encontrar tratamientos efectivos en el menor tiempo posible.
El programa desarrolla proyectos y ensayos clínicos en hospitales andaluces que permitirán conocer mejor la enfermedad y encontrar tratamientos efectivos en el menor tiempo posible.
El Programa de Investigación Clínica en Covid-19, puesto en marcha por la Consejería de Salud y Familias hace escasamente un mes, ha resuelto ya la financiación de nueve estudios científicos, entre proyectos de investigación y ensayos clínicos, para conocer mejor la enfermedad y con ello mejorar el pronóstico y tratamiento de los pacientes afectados.
En estos proyectos seleccionados participarán hospitales de todas las provincias andaluzas y se beneficiarán pacientes de manera directa, pero también a través de las conclusiones para la toma de decisiones clínicas que se extraigan de los proyectos vinculados a la epidemiología y también en el ámbito de la salud pública.
Los trabajos, que han sido seleccionados gracias a esta línea de financiación de carácter extraordinario, se centran en diferentes aspectos del nuevo coronavirus SARSCoV-2. Así, se estudiará el uso de la hidroxicloroquina en trabajadores sanitarios; la caracterización clínica-biológica-molecular de la afectación neurológica en la enfermedad; la secuenciación completa del genoma del virus SARS-CoV-2; y la prevención y el tratamiento con calcifediol del síndrome respiratorio agudo por Covid-19, entre otros.
Además, se desarrollarán ensayos clínicos multicéntricos en los que se evaluarán aspectos como la eficacia del tratamiento con plasma hiperinmune obtenido de pacientes que ya han pasado por Covid-19; la aplicación de células mesenquimales alogénicas en neumonía severa por COVID-19; o el efecto de sarilumab (un anticuerpo monoclonal humano) en adultos hospitalizados con Covid-19 que presentan síndrome de liberación de citoquinas.
De los nueve proyectos financiados, seis de ellos están comisionados a la Red ANCRAID (Red Andaluza de Investigación Clínica en Enfermedades Infecciosas), que agrupa a infectólogos, microbiólogos e intensivistas, entre otras especialidades, de los hospitales de Andalucía y que están realizando un esfuerzo extraordinario en la búsqueda de soluciones terapéuticas al Covid-19.
Financiación
En total, se han destinado 400.000 euros a financiar estos estudios científicos con los que se persigue generar investigación traslacional que contribuya a la mejora de la práctica clínica en pacientes con Covid-19, a su pronóstico y tratamiento. Se trata de proyectos de una duración máxima de cinco meses de los que se espera obtener los primeros resultados a los dos meses de su inicio.
La financiación que se ha concedido procede de los fondos para el fomento de la investigación del Servicio Andaluz de Salud puestos a disposición de este programa a través de las fundaciones de investigación de los hospitales de Andalucía. A esta financiación se unen donaciones de personas, empresas y colectivos, a quienes se les quiere agradecer públicamente su aportación y apoyo. Aunque el programa ya ha resuelto la concesión de fondos a estos nueve estudios, permanecerá abierto a más donaciones de quienes quieran colaborar.
El Programa de Investigación Clínica en Covid-19 está alineado con las iniciativas puestas en marcha a nivel nacional y europeo y responde a la importancia que tiene en estos momentos la investigación clínica para determinar de manera fiable los posibles nuevos usos para Covid-19 de medicamentos ya autorizados para otras enfermedades.






